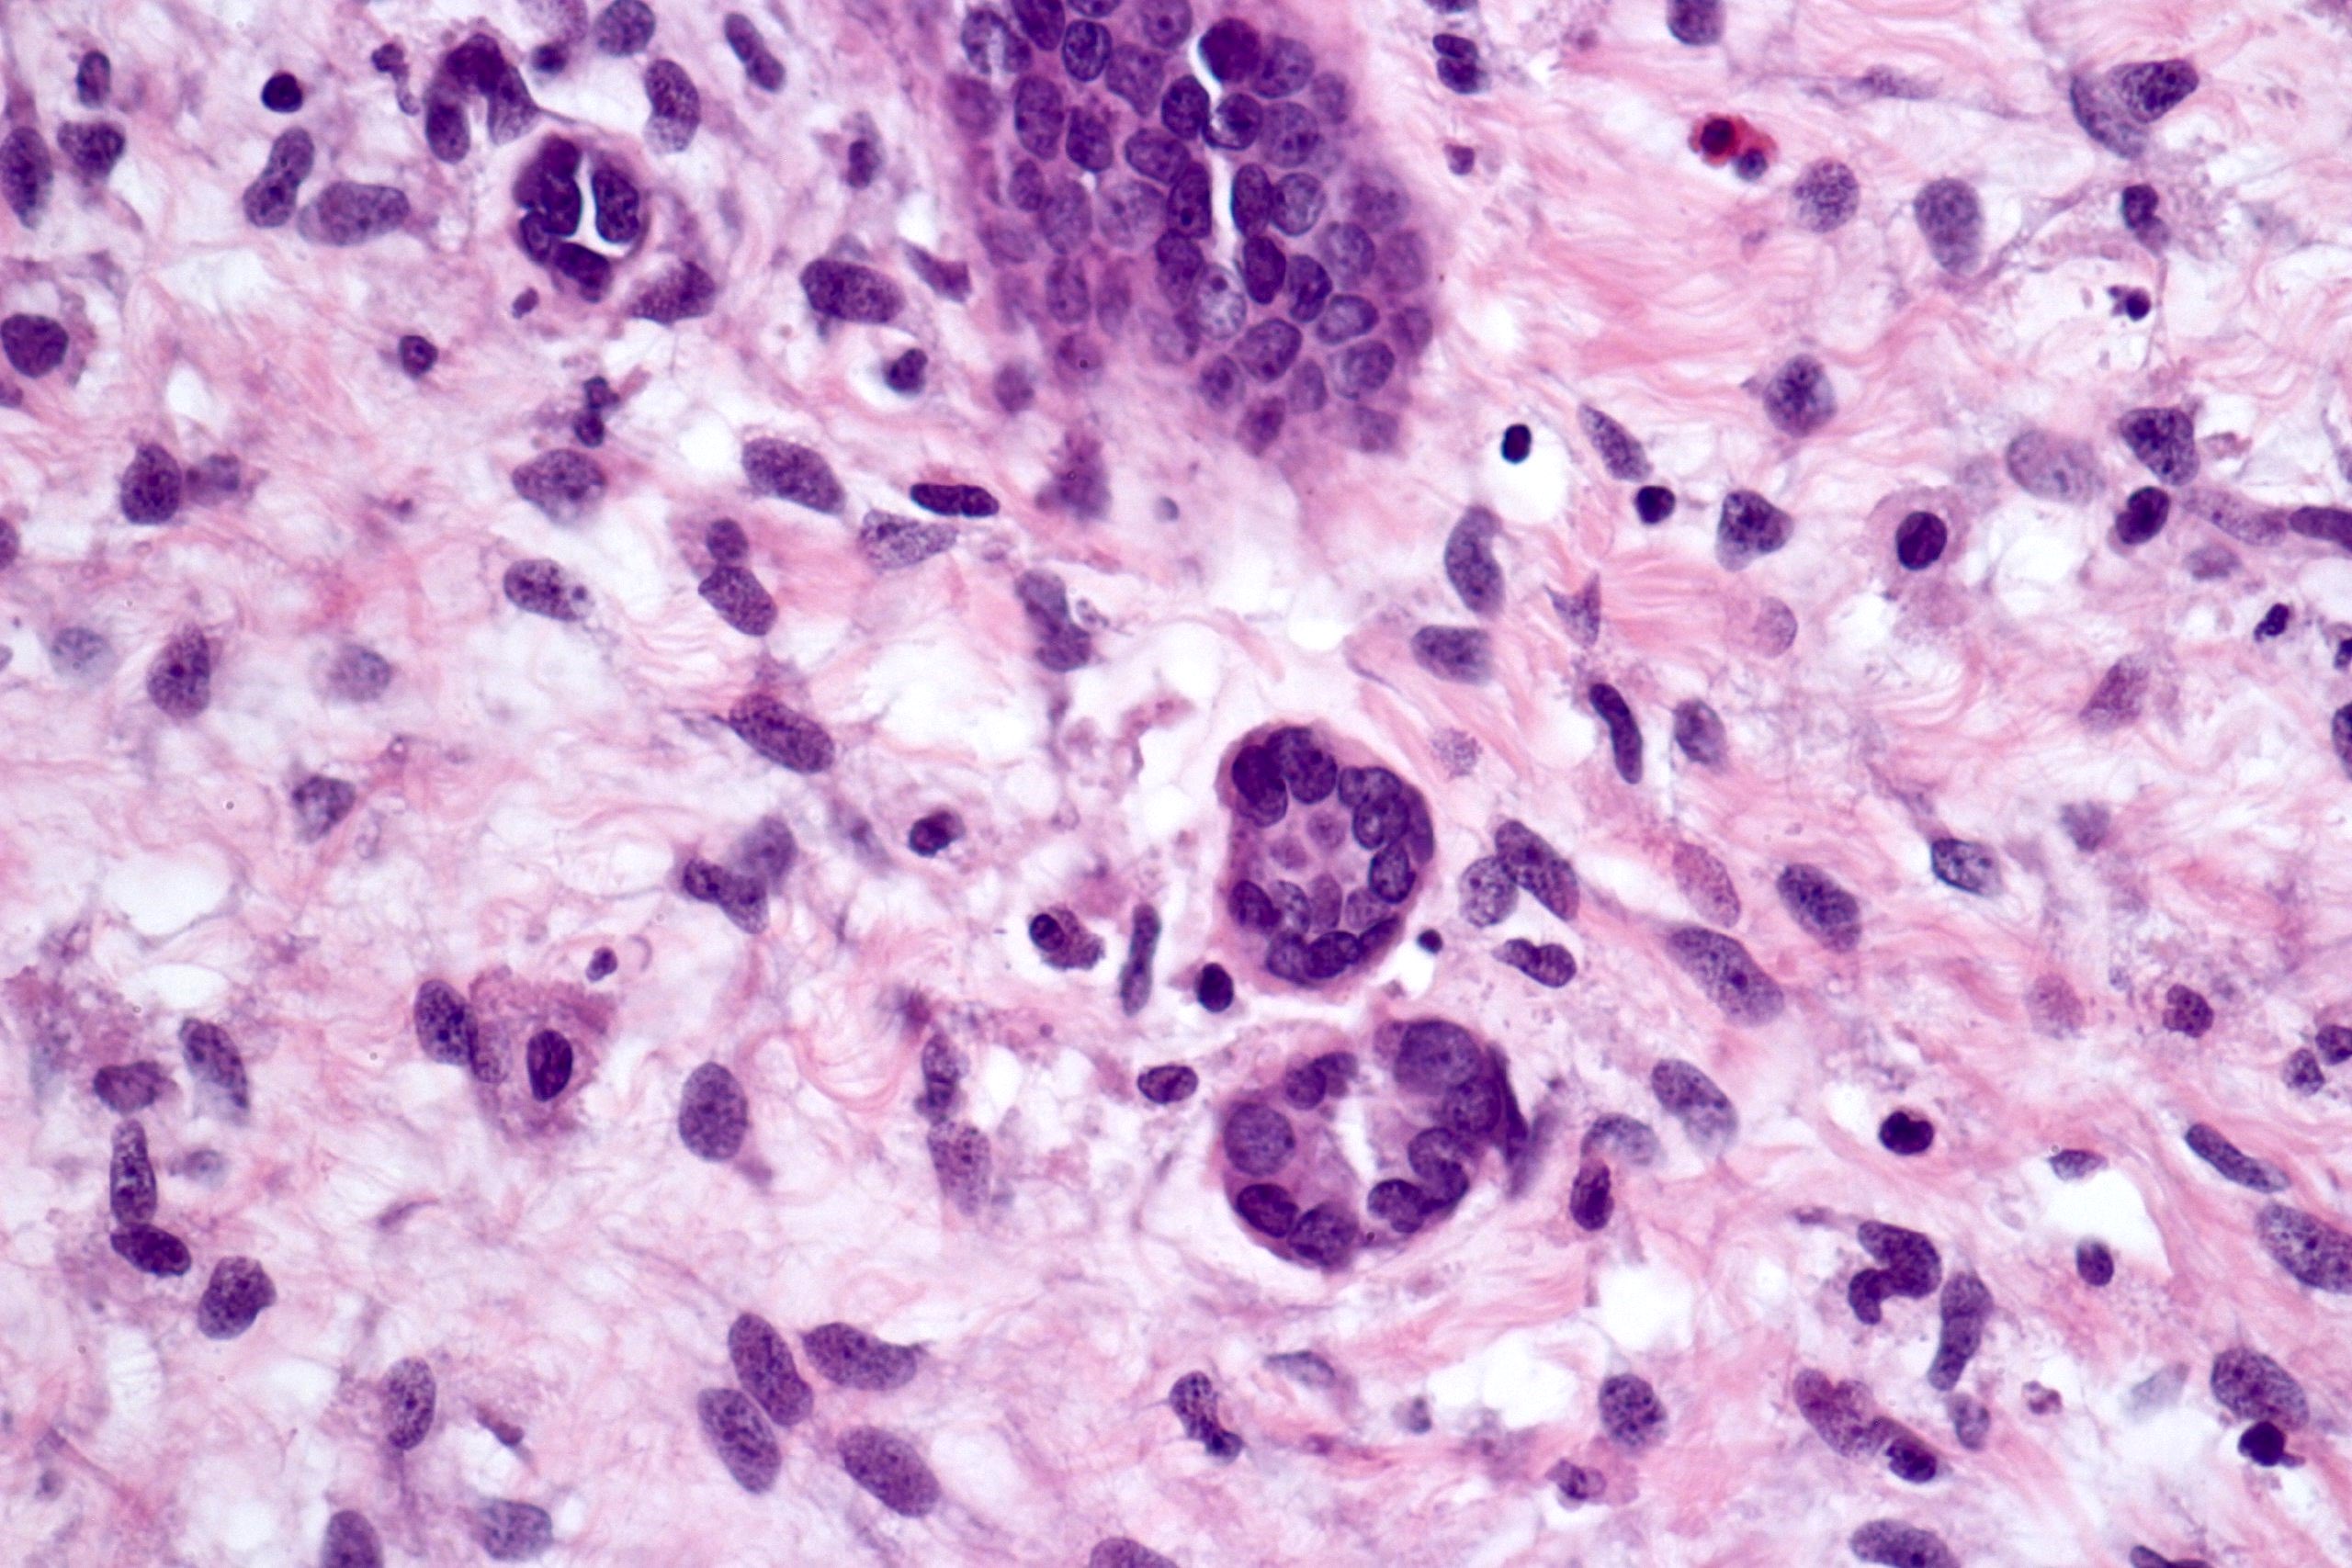

Table of Contents
Definition / general | Essential features | ICD coding | Epidemiology | Clinical features | Diagnosis | Radiology description | Radiology images | Prognostic factors | Case reports | Treatment | Gross description | Gross images | Microscopic (histologic) description | Microscopic (histologic) images | Positive stains | Molecular / cytogenetics description | Sample pathology report | Differential diagnosis | Additional references | Board review style question #1 | Board review style answer #1Cite this page: Athanazio D. Cystic partially differentiated nephroblastoma. PathologyOutlines.com website. https://www.pathologyoutlines.com/topic/kidneytumorcysticnephroblastoma.html. Accessed April 19th, 2024.
Definition / general
- WHO: multilocular, exclusively cystic neoplasm of very young children, containing nephroblastomatous tissue
- The concept was introduced as a variant of nephroblastoma curable by surgery (Perspect Pediatr Pathol 1979;5:217)
Essential features
- Entirely multilocular cystic tumor that lacks solid nodules on gross or microscopic examination; septa contain (undifferentiated) mesenchyme, blastemal and immature epithelial elements
ICD coding
- ICD-O: 8959/1 - cystic partially differentiated nephroblastoma
- ICD-11: 2C90.Y & XH1JB4 - other specified malignant neoplasms of kidney, except renal pelvis & cystic partially differentiated nephroblastoma
Epidemiology
- Rare (21 out of 5,100 cases of nephroblastoma) (J Pediatr Surg 2003;38:897)
- Occurs in children presenting before 2 years of age (Cancers (Basel) 2021;13:997)
- Male predominance
Clinical features
- Palpable abdominal mass (Cancers (Basel) 2021;13:997)
- Bilateral disease in 4.4%, 3 cases with bilateral cystic partially differentiated nephroblastoma, 2 with nephroblastomatosis in the contralateral kidney and 1 with Wilms tumor in the contralateral kidney (Cancers (Basel) 2021;13:997)
Diagnosis
- Requires microscopic examination of resected tumor
Radiology description
- Large multilocular cystic mass with septa of varying thickness
- No solid component
Radiology images
Prognostic factors
- Rare recurrences have been reported as a complication of incomplete resection or tumor rupture
- No recurrence in series with n = 21 and n = 7 (J Pediatr Surg 2003;38:897, J Urol 2007;177:294)
- Recurrences in 4 of 113 (3.5%) in a large review, however, Wilms tumor could not be ruled out in 3 cases (Cancers (Basel) 2021;13:997)
- No deaths attributable to the disease, series with n = 21, n = 7 and in a large review with n = 113 (J Pediatr Surg 2003;38:897, J Urol 2007;177:294, Cancers (Basel) 2021;13:997)
Case reports
- 4 month old boy with a multicystic mass involving the whole right kidney (Clin Case Rep 2021;9:e04929)
- 18 month old boy with bilateral CPDN (Urology 2016;92:106)
- 2 year old girl with gradually increasing painless abdominal mass (Indian J Nephrol 2013;23:460)
- 3 year old girl with 4.6 cm unilocular renal cyst (Front Pediatr 2022;10:1045936)
- 45 year old man with a 3 cm multicystic kidney mass (Int J Clin Exp Pathol 2015;8:989)
Treatment
- Surgery is almost always curative
- Patients with stage I disease are cured by surgery without adjuvant chemotherapy
- Questionable value of chemotherapy in cases of tumor rupture and spillage (Cancers (Basel) 2021;13:997)
Gross description
- Typically, a large multilocular cystic tumor (mean diameter of 10 cm)
- Thin or variable sized septa
- Well circumscribed
- No expansive nodules
- Reference: J Postgrad Med 2006;52:45
Gross images
Microscopic (histologic) description
- Cysts lined with flat / cuboidal / hobnail cells (or are denuded)
- Epithelial elements consist mainly of mature and immature / abortive tubules and small papillae resembling immature glomeruli
- Key histological findings of the variably cellular septa include
- Nephroblastomatous epithelial elements
- Islands of undifferentiated blastema and differentiated mesenchymal elements (skeletal muscle and less often cartilage and fat) (J Urol 2010;183:1585)
- Focally, the septal elements may protrude into the cystic spaces in microscopic papillary folds
Microscopic (histologic) images
Contributed by Americo Brilhante, M.D. and Daniel Athanazio, M.D., Ph.D.
Positive stains
- WT1: blastemal cells (J Cancer Res Ther 2022;18:209)
- Immunohistochemistry for other markers is poorly described and not relevant for the diagnosis
Molecular / cytogenetics description
- Cystic partially differentiated nephroblastoma is considered part of the nephroblastoma spectrum
- Does not harbor DICER1 mutations, which are found in the morphologically similar tumor pediatric cystic nephroma (Cancers (Basel) 2021;13:997)
- No specific genetic alterations have been characterized (Cancers (Basel) 2021;13:997)
Sample pathology report
- Left kidney, nephrectomy:
- Cystic partially differentiated nephroblastoma (see synoptic report)
Differential diagnosis
- Multicystic renal dysplasia:
- Typically, obstructive symptoms are present
- Usually diffuse and bilateral
- Presence of primitive ducts on histology, metaplastic cartilage and lobar disorganization (Arch Pathol Lab Med 2015;139:547)
- Pediatric cystic nephroma:
- Also an exclusively cystic renal neoplasm
- Septa do not contain nephroblastomatosis and extensive sampling is required to exclude nephroblastomatosis elements (Amin: Urological Pathology, 1st Edition, 2014)
- Does not contain ovarian type stroma
- Associated with DICER1 mutations
- Wilms tumor (nephroblastoma):
- Although it may be extensively cystic, it shows expansive nodules with nephroblastomatous component (Nat Rev Urol 2018;15:693)
- Predominately solid areas containing focally cystic areas
- Careful grossing sampling is required to identify expansive nodules (Amin: Urological Pathology, 1st Edition, 2014)
- Also WT1+
- Has malignant behavior
Additional references
Board review style question #1
A large multilocular cystic renal mass was removed from an 18 month old boy. The differential diagnosis is pediatric cystic nephroma and cystic partially differentiated nephroblastoma. What finding within the septa favors cystic partially differentiated nephroblastoma?
- Fibrous tissue
- Nephroblastomatous elements
- Presence of mature renal cortex within the septa
- Tubules with flat and hobnail morphology
Board review style answer #1
B. Nephroblastomatous elements. The presence of nephroblastomatous elements within septa is the major criterion for distinction between cystic partially differentiated nephroblastoma and cystic nephroma. Answer D is incorrect because flat and hobnail lining do not distinguish both lesions. Answer C is incorrect because residual cortical parenchyma may be observed between cysts in autosomal dominant polycystic kidney disease. Answer A is incorrect because the presence of fibrous tissue within septa would not distinguish the entities in this differential.
Comment Here
Reference: Cystic partially differentiated nephroblastoma
Comment Here
Reference: Cystic partially differentiated nephroblastoma